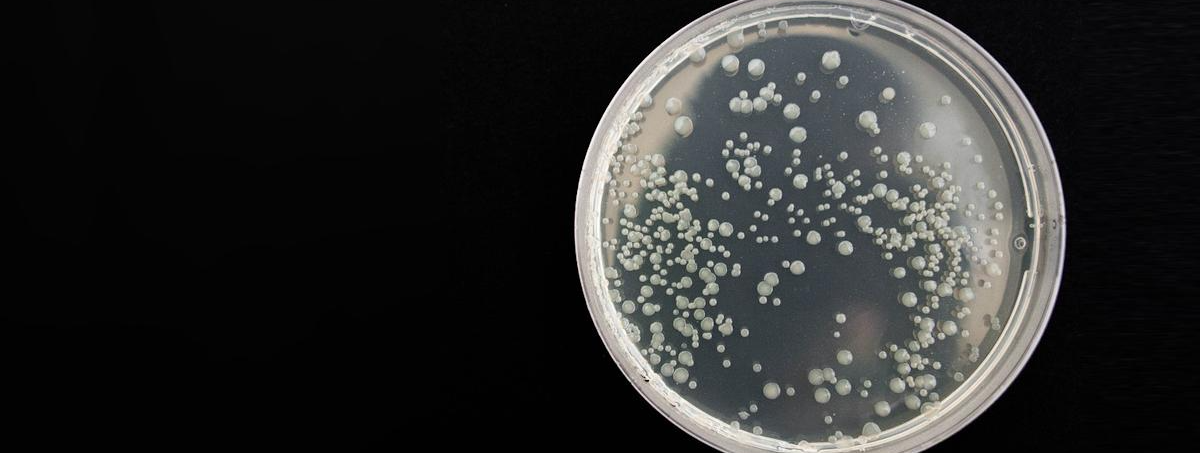

Roche is fast-tracking a new antibiotic, zosurabalpin, into phase 3 trials to combat carbapenem-resistant Acinetobacter baumannii—a hospital-acquired ‘superbug’ the CDC calls an urgent threat. If successful, it would be the first novel treatment for Gram-negative bacterial infections in half a century.
Targeting a pathogen the WHO ranks among the highest global health priorities, the drug disrupts the bacterial membrane-building process, killing the bacteria without triggering known resistance mechanisms. This makes it a high-potential weapon in the race to contain antimicrobial resistance (AMR), a looming public health crisis projected to rival cancer in global mortality by 2050.
The move signals a bold shift from Roche as the pharma industry steps cautiously around low-return antibiotic development. Governments like the UK are rethinking the economic model with annual payment schemes to incentivise innovation, and drugs like zosurabalpin could be early beneficiaries.
Read the full article to see what this means for the future of AMR and pharma investment.

.png)

